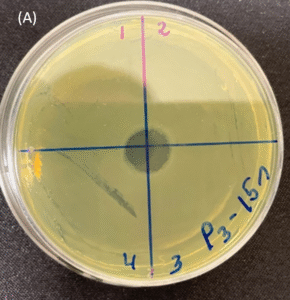
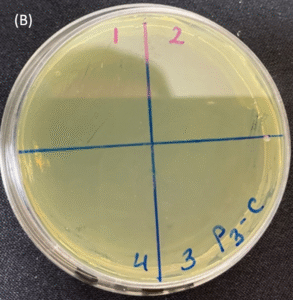
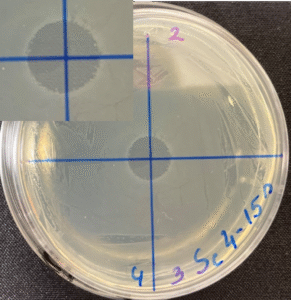
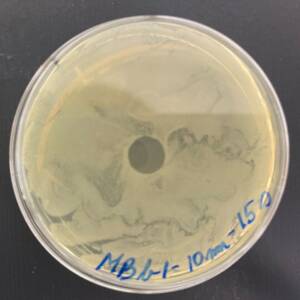
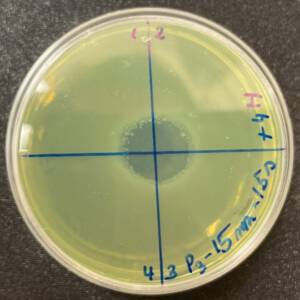
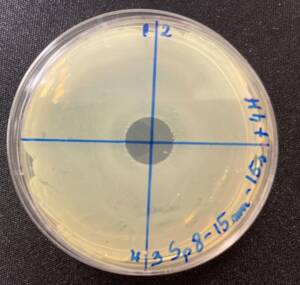
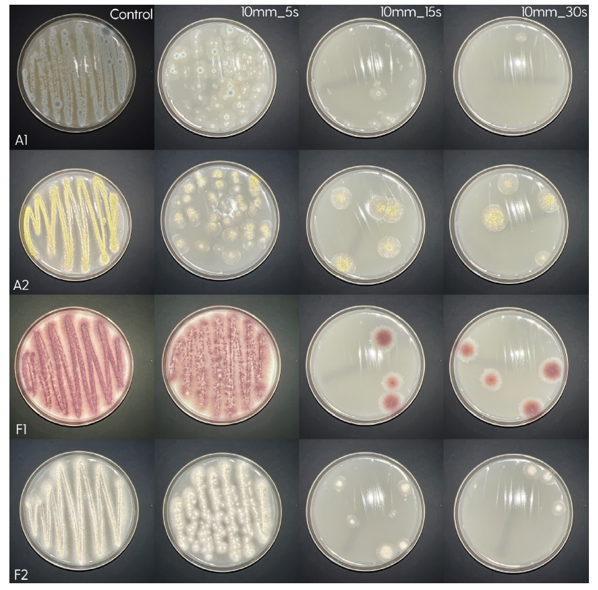
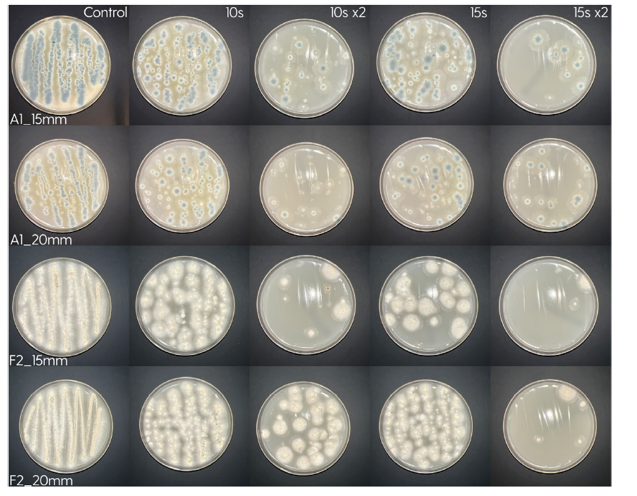

Take a Look
For transparency and scientific grounding, we invite you to explore the published studies that support our work.
01.Melan - 100 Research
02. Ocu Vet UV-C Research
Scientific References
Our research and clinical insights are supported by peer-reviewed scientific studies and published literature. Below you can explore two categories of references:
- Chromatic Pupillometry & Vision Studies – highlighting research on color vision, pupillary reflexes, and diagnostic tools in veterinary and human ophthalmology.
- UV-C Therapy Studies – focusing on innovative ultraviolet C light applications for treating corneal infections and advancing ocular health.
These references provide the scientific foundation behind our work and reflect the continuous progress in ophthalmic research.
Scientific Papers MELAN -100
Scientific Papers (References)
- Neitz J, Geist T, Jacobs GH. Color vision in the dog. Vis Neurosci. 1989 Aug;3(2):119-25. doi: 10.1017/s0952523800004430. PMID: 2487095;
- S. D. Grozdanic, M. Matic, D. S. Sakaguchi, and R. H. Kardon, “Evaluation of Retinal Status Using Chromatic Pupil Light Reflex Activity in Healthy and Diseased Canine Eyes,” Investigative Ophthalmology & Visual Science 48, no. 11 (2007): 5178–5183;
- K. Terakado, T. Yogo, Y. Nezu, Y. Harada, Y. Hara, and M. Tagawa, “Efficacy of the Use of a Colorimetric Pupil Light Reflex Device in the Diagnosis of Fundus Disease or Optic Pathway Disease in Dogs,” Journal of Veterinary Medical Science 75, no. 11 (2013): 1491–1495;
- C. Yeh, K. L. Koehl, C. Harman, et al., “Assessment of Rod, Cone, and Intrinsically Photosensitive Retinal Ganglion Cell (ipRGC) Contribution to the Canine Chromatic Pupillary Response,” Investigative Ophthalmology & Visual Science 56, no. 7 (2015): 5569;
- S. D. Grozdanic, H. Kecova, and T. Lazic, “Rapid Diagnosis of Retina and Optic Nerve Abnormalities in Canine Patients With and Without Cataracts Using Chromatic Pupil Light Reflex Testing,” Veterinary Ophthalmology 16, no. 5 (2013): 329–340;
- Santifort K, Plonek M, Görig C, Huver I. Chromatic Pupillary Light Reflex in Two Dogs With Amaurosis Secondary to Optic Pathway Disorders. Vet Ophthalmol. 2025 Feb 24. doi: 10.1111/vop.70010. Epub ahead of print. PMID: 39993949;
- Elyse M. Salpeter, Ala Moshiri, Michelle Ferneding, Monica J. Motta, Sangwan Park, Chrisoula Skouritakis, Sara M. Thomasy. Chromatic Pupillometry as a Putative Screening Tool for Heritable Retinal Disease in Rhesus Macaques. Trans. Vis. Sci. Tech. 2023;12(6):13. https://doi.org/10.1167/tvst.12.6.13;
- Kardon R, Anderson SC, Damarjian TG, Grace EM, Stone E, Kawasaki A. Chromatic pupil responses: preferential activation of the melanopsin-mediated versus outer photoreceptor-mediated pupil light reflex. Ophthalmology. 2009; 116: 1564–1573;
- Collison FT, Park JC, Fishman GA, McAnany JJ, Stone EM. Full-field pupillary light responses, luminance thresholds, and light discomfort thresholds in CEP290 Leber congenital amaurosis patients. Invest Ophthalmol Vis Sci. 2015; 56: 7130–7136.
Scientific Papers Ocu Vet UV-C
Scientific Papers (UV-C Studies)
- Turicea B, Sahoo DK, Allbaugh RA, Stinman CC, Kubai MA. Novel treatment of infectious keratitis in canine corneas using ultraviolet C (UV-C) light. Vet Ophthalmol. 2024;00:1-15. doi:10.1111/vop.13265;
- Marasini S. Exploring the Potential of UVC in Treating Superficial Corneal Infections (PhD Thesis). The University of Auckland; 2019;
- Hoerdemann M, Sahoo DK, Allbaugh RA, Kubai MA. Ultraviolet C (UV-C) Light Therapy for Equine Ulcerative Keratomycosis—An In Vitro Study. Vet Ophthalmol. 2025 Mar 5; doi:10.1111/vop.70012;
- Marasini S, Dean SJ, Swift S, et al. Preclinical confirmation of UVC efficacy in treating infectious keratitis. Ocul Surf. 2022;25:76–86. doi:10.1016/j.jtos.2022.05.004;
- B. Turicea, D. K. Sahoo, R. A. Allbaugh, C. C. Stinman, and M. A. Kubai. Antimicrobial Activity of Ultraviolet C Light as a Potential Novel Treatment for Moraxella bovis Infection—An In Vitro Study. Vet Ophthalmol. 2025;0:1–11. doi:10.1111/vop.70087;
- Dean SJ, Petty A, Swift S, et al. Efficacy and safety assessment of a novel ultraviolet C device for treating corneal bacterial infections. Clin Exp Ophthalmol. 2011;39(2):156–163. doi:10.1111/j.1442-9071.2010.02471;
- Marasini S, Mugisho OO, Swift S, et al. Effect of therapeutic UVC on corneal DNA. Safety assessment for potential keratitis treatment. Ocul Surf. 2021;20:130–138. doi:10.1016/j.jtos.2021.02.005;
- Kaidzu S, Sugihara K, Sasaki M, Nishiaki A, Igarashi T, Tanito M. Evaluation of acute corneal damage induced by 222-nm and 254-nm ultraviolet light in Sprague-Dawley rats. Free Radic Res. 2019;53(6):611–617. doi:10.1080/10715762.2019.1603378.
Our UV-C Research
This study investigates the efficacy of Ultraviolet C (UV-C) light therapy as a potential treatment for bacterial keratitis. Conducted under controlled in vitro conditions, the research evaluates the antimicrobial activity and safety of UV-C exposure on affected corneal tissue. The findings contribute to the growing body of evidence supporting UV-C therapy as a non-invasive and targeted approach for managing severe corneal infections in veterinary ophthalmology.


Treatment of the Petri plates inoculated with live bacteria using Ocu-Vet UV-C for 15 seconds at a 10 mm distance.

Photos of the Petri plates, 72 hours after bacterial (Pseudomonas aeruginosa) inoculation.
Image (A) shows positive bacterial growth inhibition (full translucency) at the treatment site after one dose of
UV-C for 15 seconds at 10 mm distance.
Image (B) is the control plate. The blue lines divide the plate into quadrants.
Photos of the Petri plates, 72 hours after bacterial (Streptococcus canis) inoculation.
The image and the inset show complete (positive) bacterial growth inhibition (full translucency)
at the treatment site after one dose of UV-C for 15 seconds at a 10 mm distance.
The blue lines divide the plate into quadrants.
Photo of the Petri plate, 72 hours after bacterial (Moraxella bovis) inoculation. The image shows complete (positive) bacterial growth inhibition (full translucency) at the treatment site after one dose of UV-C for 15 seconds at a 10 mm distance.
The diameter of the area of inhibition, measured with calipers:
– 8 mm (7 mm for Staphylococcus isolates) at 15 seconds.



Microscopic images (4× objective, 5× magnification, Olympus cellSens Standard software) of the central area inoculated with Pseudomonas aeruginosa and treated with UV-C for 15 seconds (A) and the control area (B). A clear demarcation of the treated area can be seen on image (A).

Photos of the Petri plates, 72 hours after bacterial inoculation. Both plates show complete (positive) bacterial growth inhibition (full translucency) at the treatment site after two UV-C doses of 15 seconds at a 15 mm distance. The blue lines divide the plate into quadrants.


Mimicking a superficial ulcer by scoring and removing the epithelium and anterior stroma of the canine cornea. Fluorescein staining was used to confirm the presence of the superficial ulcer.
Canine cornea inoculated superficially on the ulcer bed with live Pseudomonas aeruginosa bacteria.



Storage of inoculated cornea and control in the incubator for 24 hours. The corneas are immersed in a storage solution to prevent desiccation. The image shows an inoculated cornea with live bacteria.
Treatment of the inoculated cornea with UV-C for 15 seconds at a distance of 10 mm.


Staphylococcus pseudintermedius – Superficial fluorescence microscope images showing Staphylococcus pseudintermedius inoculated on the cornea, treated with UV-C for 15 seconds at a 10 mm distance.

Streptococcus canis – Superficial fluorescence microscopy. Each image is divided into four quadrants: the upper left quadrant shows the green channel highlighting live bacteria; the upper right shows the red channel highlighting dead bacteria; the bottom right shows the merged green and red channels indicating live and dead bacteria; and the bottom left illustrates the bright field image. Bright green represents bacteria with intact membranes (live), red represents bacteria with compromised or dead membranes, and yellow represents bacteria with partially compromised membranes. Scale bar: 15 µm.

Pseudomonas aeruginosa – Superficial fluorescence microscopy. Microscopic imaging of Pseudomonas aeruginosa inoculated on the corneal surface and treated with UV-C for 15 seconds at a 10 mm distance. The images show clear bacterial membrane disruption and reduced viability, demonstrating the antimicrobial effectiveness of UV-C treatment on the superficial corneal layer.

Each image is divided into four quadrants: the upper left quadrant shows the green channel highlighting live bacteria; the upper right shows the red channel highlighting dead bacteria; the bottom right shows the merged green and red channels indicating live and dead bacteria; and the bottom left illustrates the bright field image. Bright green represents bacteria with intact membranes (live bacteria), red represents bacteria with compromised or dead membranes, and yellow represents bacteria with partially compromised membranes. Scale bar: 15 µm.

Panel with fluorescence microscope images of Pseudomonas aeruginosa (A & B), Streptococcus canis (C & D), Staphylococcus pseudintermedius (E & F), and a polymicrobial mix (G & H) inoculated superficially and treated with UV-C for 15 seconds.
Control samples are represented by images A, C, E, and G, and treated samples by images B, D, F, and H.
Each image is divided into four quadrants: the upper left quadrant shows the green channel highlighting live bacteria; the upper right shows the red channel highlighting dead bacteria; the bottom right shows the merged green and red channels highlighting live and dead bacteria; and the bottom left illustrates the bright field image. Bright green represents bacteria with intact membranes (live), red represents bacteria with compromised or dead membranes, and yellow represents bacteria with partially compromised membranes. Scale bar: 15 µm.

Fluorescence microscope images of the treated area with UV-C for 15 seconds (magnification 5×).
Each image is divided into four quadrants: the upper left quadrant shows the green channel highlighting live bacteria; the upper right shows the red channel highlighting dead bacteria; the bottom right shows the merged green and red channels indicating live and dead bacteria; and the bottom left illustrates the bright field image. Bright green represents bacteria with intact membranes (live bacteria), red represents bacteria with compromised or dead membranes, and yellow represents bacteria with partially compromised membranes.
It is noticeable that the central UV-C treated area contains predominantly dead bacteria, surrounded by live bacteria in the untreated area.
Hoerdemann M, Sahoo D.K., Allbaugh R.A., Kubai M.A. Ultraviolet C (UV-C) Light Therapy for Equine Ulcerative Keratomycosis – An In Vitro Study. Veterinary Ophthalmology. March 5, 2025; doi:10.1111/vop.70012.
Hoerdemann M., Sahoo D.K., Allbaugh R.A., Kubai M.A. Ultraviolet C (UV-C) Light Therapy for Equine Ulcerative Keratomycosis – An In Vitro Study. Veterinary Ophthalmology. March 5, 2025; doi:10.1111/vop.70012.
Focused on customer confidence
Our device is designed to support the treatment of corneal infections by providing an innovative adjunct therapy that complements standard medical approaches.
Yes. Safety is a key priority. The device has been developed with built-in protective measures and protocols, and its use is supported by peer-reviewed research in veterinary ophthalmology.
We encourage you to review the scientific papers referenced on this site, which provide detailed data and evidence supporting the clinical use of our technology.



